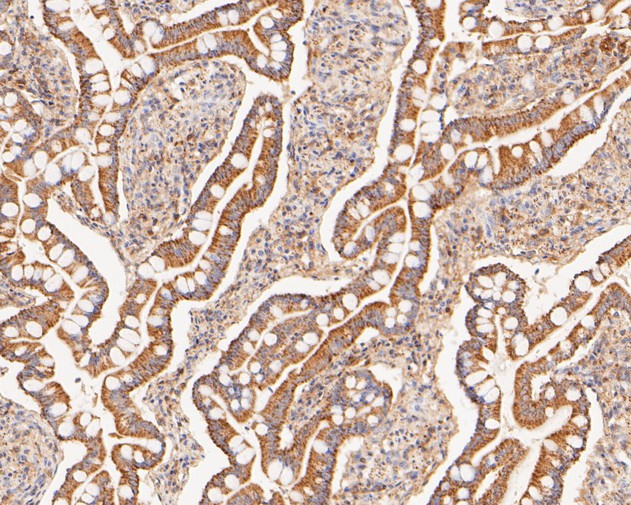
COX5B Antibody in Immunohistochemistry (Paraffin) (IHC (P))

Search
Invitrogen
COX5B Polyclonal Antibody
{{$productOrderCtrl.translations['antibody.pdp.commerceCard.promotion.promotions']}}
{{$productOrderCtrl.translations['antibody.pdp.commerceCard.promotion.viewpromo']}}
{{$productOrderCtrl.translations['antibody.pdp.commerceCard.promotion.promocode']}}: {{promo.promoCode}} {{promo.promoTitle}} {{promo.promoDescription}}. {{$productOrderCtrl.translations['antibody.pdp.commerceCard.promotion.learnmore']}}
图: 1 / 6
COX5B Antibody (PA5-116487) in IHC (P)






Please note: We are reviewing Western blot images included in the antibody testing data in our catalog, including those provided by third parties. Unless expressly labeled or annotated as “raw-unedited”, Western blot images included in the antibody testing data in our catalog may have been edited, optimized or otherwise adjusted for presentation.
产品信息
PA5-116487
种属反应
宿主/亚型
分类
类型
抗原
偶联物
形式
浓度
规格
纯化类型
保存液
内含物
保存条件
运输条件
RRID
产品详细信息
Positive controls: 293 cell lysates, human liver tissue, human liver carcinoma tissue, human kidney tissue, human small intestine tissue, HepG2.
靶标信息
The cytochrome c oxidase (COX) family of proteins function as the final electron donor in the respiratory chain to drive a proton gradient across the inner mitochondrial membrane, ultimately resulting in the production of water. The mammalian COX apoenzyme is a dimer, with each monomer consisting of 13 subunits, some of which are mitochondrial and some of which are nuclear. Found in the inner mitochondrial membrane, COX5 is the heme A-containing chain of the oxidase family that converts one molecule of oxygen and four molecules of hydrogen to two molecules of water. Two isoforms of COX5 exist, COX5a and COX5b. When oxygen levels within the cell are high, transcription of COX5a (the aerobic isoform) is up-regulated as the rate of cellular respiration increases. Conversely, when oxygen levels are low, COX5b (the hypoxic isoform) transcription increases and functions to maximize the turnover rate of the COX apoenzyme.
仅用于科研。不用于诊断过程。未经明确授权不得转售。
篇参考文献 (0)
生物信息学
蛋白别名: Cytochrome c oxidase polypeptide Vb; Cytochrome c oxidase subunit 5B, mitochondrial
基因别名: COX5B
Entrez Gene ID: (Human) 1329